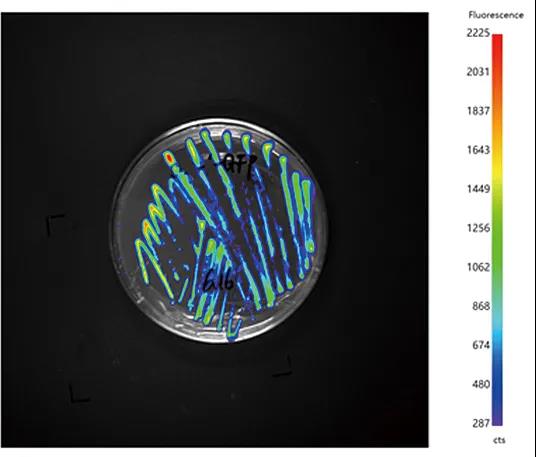

博鷺騰期待與您相會第四屆全國植物逆境生物學研討會

為展示我國植物逆境生物學研究的最新成果,促進我國植物逆境生物學研究和科研人員之間的交流合作,第四屆全國植物逆境生物學學術研討會于2021年5月31日—6月3日在上海召開,會議主題為“從逆境感受到應用技術”。會議由中科院上海植物逆境生物學研究中心、中國農業大學植物生理學與生物化學國家重點實驗室、河南大學省部共建作物逆境適應與改良國家重點實驗室、西北農林科技大學旱區作物逆境生物學國家重點實驗室、中國植物生理與植物分子生物學會環境生理和營養生理專業委員會、中國植物學會植物生理與分子生物學專業委員會聯合主辦。
博鷺騰相邀
廣州博鷺騰生物科技有限公司作為一家專業的光子檢測設備公司,秉承“科技創新、品質領先、服務大眾”的理念,在2018年底推出PlantView100植物活體成像系統,廣泛應用于植物基因表達和蛋白質之間相互作用研究、抗逆性研究、基因脅迫實驗、生長規律及節律監測、克隆篩選、基因育種篩選、葉綠素監測、藥用植物篩選以及植物細菌和病毒感染研究等領域。
博鷺騰不斷進行創新和超越,將產品持續更新迭代,屆時博鷺騰2021年最新升級版PlantView100植物活體成像系統將在現場展示,歡迎各位專家、學者前來參觀交流。
我們期待您的蒞臨!
會議信息
會議地址
酒店:上海富悅大酒店(主樓三樓)
地址:上海市松江區茸悅路208弄
會議日程
5月31日 會議報到
6月1-2日 學術報告
6月3日上午 離會
主要內容
1. 植物逆境感應與信號轉導
2. 植物細胞器與逆境應答
3. 植物發育可塑性與逆境適應
4. 植物營養逆境
5. 逆境生物技術
展位信息

PlantView100植物活體成像系統

應用實例
|
 |
| 菌種篩選(GFP) | 植物全株基因表達(Luc) |
 |
 |
| 蛋白互作(Luc) | 病毒侵染(Luc) |
 |
 |
| 植物防御機制(Luc) | 葉綠素熒光 |
- CGT Asia 第十屆亞洲細胞與基因治療創新峰會通知
- BIOCHINA2026第十一屆易貿生物產業展覽注冊已開啟
- 禮智生物將亮相大灣區腦病中醫藥科創與產學研大會
- NEW-MED 2026生物材料研發及應用峰會通知
- 隱智科儀攜智能儀器解決方案亮相華人生物分析論壇
- 2026生物農藥研發創制與農藥制劑加工研討會通知
- 2026第八屆國際功能醫學創新大會通知
- CGLTS2025北京細胞與基因免疫治療亦莊峰會通知
- 第11屆全國植物生物學與植物逆境生物學研討會通知
- 2026作物高產高效栽培與生態耕作學術研討會通知
- 2026廣西臨床檢驗儀器、試劑與輸血用品展覽會通知
- 北京基爾比攜類器官科研儀器參加BSCB2025學術年會
- 華威中儀邀您參加2025全國海洋微生物學學術研討會
- CBIC 2026細胞生物產業大會邀請函
- 霍爾斯攜經典發酵罐及切向流超濾系統亮相BioONE2025
- Horticulturae為植物生命分析儀團隊開辦專題直播
- 第11屆全國植物生物學與植物逆境生物學研討會通知
- 中天智感植物生命分析儀入選農業部“火花技術”成果
- 勤翔IVScope植物活體成像助力IFS轉錄調控機制研究
- 易科泰生態技術公司祝賀第24屆生態學大會圓滿召開
- 易科泰高新技術三度斬獲農高會“后稷獎”
- 易科泰應邀參加中國園藝學會 2025 年學術年會
- 易科泰邀您參加2025 農產品貯藏加工科技交流大會
- 易科泰邀您參加中國園藝學會2025年學術年會
- 易科泰葉綠素熒光成像技術助力全球荒漠化治理
- 2025全國植物組織培育研究與快繁技術研討會邀請函
- 易科泰邀您相聚寧波智博會,聚焦 AI+農業落地實踐
- 易科泰邀您參加第21次全國小麥栽培科學學術研討會
- 泛勝科技亮相第21次屆全國小麥栽培學術研討會
- 博鷺騰誠邀蒞臨2025中國植物生理與分子生物學年會
Copyright(C) 1998-2025 生物器材網 電話:021-64166852;13621656896 E-mail:info@bio-equip.com







